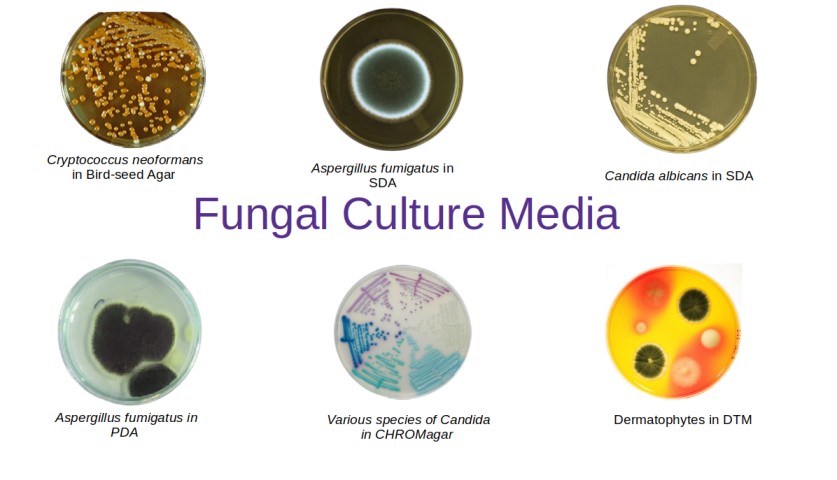
- Common fungal culture media
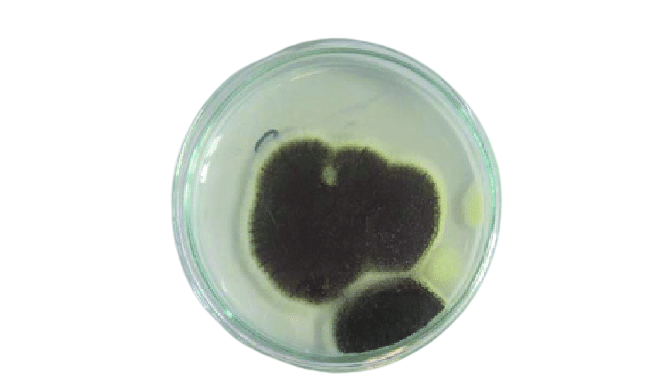

Two general types of culture media are essential to ensure the primary recovery of all clinically significant fungi from clinical specimens. One medium should be non-selective (such as brain heart infusion agar; i.e., one that will permit the growth of virtually all clinically relevant fungi) and other media should be selective, specially tailored to isolate specific pathogenic fungi of interest.
For optimal recovery of the fungal pathogen, a battery of media should be used, and the followings are recommended:
- Media with or without cycloheximide (cycloheximide is added to inhibit the growth of rapidly growing contaminating molds.)
- Media with or without an antibacterial agent (chloramphenicol, gentamicin, and ciprofloxacin are commonly used antibacterial for this purpose).
Antibacterial agents are used to killing the contaminating bacterial species. If the sample is taken from a sterile site, it is not necessary to use media containing antibacterial agents.
Common Fungal Culture Media
| Fungal Culture Media | Essential ingredients | Intended use |
|---|---|---|
| Birdseed agar | Guizotia abyssinica seeds, glucose, creatinine, chloramphenicol, monopotassium phosphate, agar | Selective and differential isolation of Cryptococcus neoformans from clinical specimens. |
| Brain-heart infusion agar | Brain heart infusion, glucose, L-cysteine hydrochloride, agar | Growth of fastidious pathogenic fungi such as Histoplasma capsulatum and Blastomyces dermatitidis . |
| CHROMagar Candida medium | Peptone, glucose, chloramphenicol, ‘Chromogenic ix’, agar | Selective and differential chromogenic medium for the isolation and identification of various Candida species |
| Cornmeal agar/ Cornmeal tween agar | Cornmeal, Tween 80, agar | Identification of C. albicans by microscopic morphology or chlamydospore production. |
| Czapek-Dox agar | NaNO 3 , K 2 HO 4 , KCl, MgSO 4 , FeSO 4 , glucose, agar | Identification of Aspergillus and P enicillium species. It can also be used for chlamydospore production by Candida albicans. |
| Dermatophyte test medium (DTM) | Soy peptone, dextrose, cycloheximide, chloramphenicol, gentamicin sulfate, phenol red, agar | Primary and differential fungal cultures medium to isolate and identify dermatophytes. |
| Inhibitory mold agar (IMA) | Tryptone, beef extract, yeast extract, starch, dextrin, chloramphenicol, gentamicin, and saline buffer | Primary recovery of pathogenic fungi exclusive of dermatophytes. |
| Mycosel/mycobiotic agar | Papaic digest of soybean meal, dextrose, cycloheximide, chloramphenicol, agar | Highly selective medium; recommended for the isolation of pathogenic fungi from materials containing a large amount of fungal and bacterial flora. |
| Potato dextrose agar (PDA) | Potato extract, potato infusion, dextrose, agar | Ideal medium for slide culture preparation. It promotes sporulation of dermatophytes. Demonstration of pigment production by T. rubrum. |
| Potato flake agar | Potato flakes, dextrose, agar | Primary recovery of saprophytic and pathogenic fungi. |
| Rice starch agar | Cream of rice, Tween 80, agar | Production of chlamydospore in Candida albicans |
| Sabouraud dextrose agar (SDA) | Pancreatic digest of casein, glucose, agar | Growth and maintenance of clinically important fungal pathogens. |
Brain-heart infusion (BHI) agar
It is a non-selective fungal culture medium that permits the growth of virtually all clinically relevant fungi. It is used for the primary recovery of saprophytic and dimorphic fungi.
Czapek dox agar
Czapek dox agar is a semisynthetic medium containing sodium nitrate as the sole source of nitrogen. It is used for the subculture of Aspergillusspecies for their differential diagnosis.
Inhibitory mold agar (IMA)
Inhibitory mold agar (IMA) is an enriched medium containing chloramphenicol (with some formulations containing gentamicin). Â It supports the growth of a wide range of fungi and may inhibit bacterial growth due to its antibiotic content. It is used for the primary recovery of dimorphic pathogenic fungi. Saprophytic fungi and dermatophytes will not be recovered.
Mycosel/Mycobiotic agar
- It is generally Sabouraud’s dextrose agar with cycloheximide and chloramphenicol added.
- It is used for the primary recovery of dermatophytes.
Niger Seed Agar
It is used for the identification of Cryptococcus neoformans.
Potato Dextrose Agar (PDA)
Potato Dextrose Agar (PDA) is a common fungal growth media made from an infusion of potato and dextrose. It can be supplemented with acid or antibiotics to inhibit bacterial growth. It is recommended for plate count methods for microbial testings of foods, dairy products, and cosmetics.
Sabouraud’s Heart Infusion (SABHI) agar
Primary recovery of saprophytic and dimorphic fungi, particularly fastidious strains.

Sabouraud’s dextrose agar (SDA)
- Sabouraud’s agar is sufficient for the recovery of dermatophytes from cutaneous samples and yeasts from genital cultures.
- Not recommended as a primary isolation medium because it is insufficiently rich to recover certain fastidious pathogenic species, particularly most of the dimorphic fungi.
-  Sabouraud’s dextrose agar (2%) is most useful as a medium for the subculture of fungi recovered on enriched medium to enhance typical sporulation and provide the more characteristic colony morphology.
Potato flake agar
Primary recovery of saprophytic and dimorphic fungi, particularly fastidious and slow-growing strains.
Further reading and sources
- **Koneman’s color atlas and textbook of diagnostic microbiologyand
- **Bailey and Scott’s Diagnostic Microbiology.